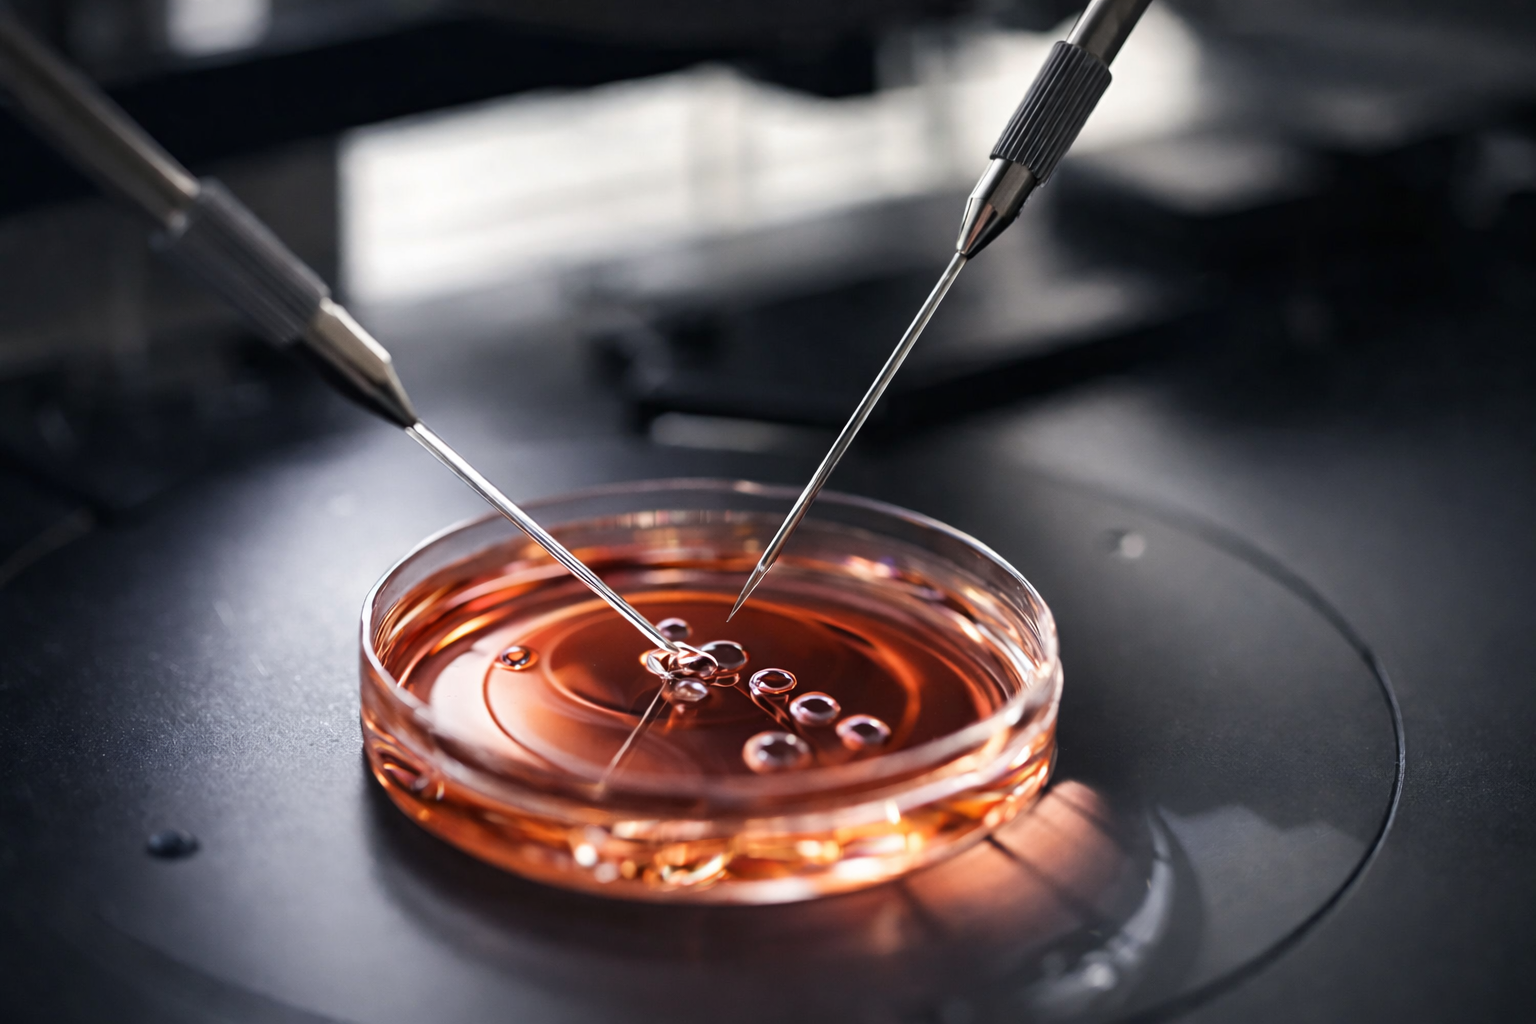
再生医療関連支援事業

事業内容 Service
株式会社ReGENETは、再生医療における豊富な実務経験と専門知識をもとに、細胞加工施設の構築、機器調達、申請支援、運用・人材育成までを一貫してサポートする専門コンサルティング会社です。制度要件と現場運用の双方を踏まえ、実行可能性を重視した支援により、無理のない事業立ち上げと安定した運用を支援します。
再生医療関連支援事業
再生医療法対応のCPC構築・運用・教育支援
細胞培養現場で管理(製造・衛生・品質)を長年経験した細胞加工の専門家が一から設計に携わり、再生医療等安全性確保法に準拠したコンパクトかつ効率的なCPC を提案致します。
●再生医療治療導入支援
(「再生医療等提供計画」書類作成サポートなど)
●細胞加工施設導入支援
(機器選定・設計・工事手配・届出関係など)
●細胞加工施設管理・運営支援
(人材紹介・培養士育成など)
●細胞加工施設維持・管理支援
(各種バリテーション、サニテーションなど)
●研究開発支援
(細胞培養技術開発、研究開発など)

理化学機器・消耗品販売事業
現場に適した 機器・消耗品を安心・確実に提供
ReGENETは、アズワン株式会社の正規販売代理店として、研究機関・医療機関向けの理化学機器および各種消耗品の販売を行っています。
再生医療分野や細胞培養の現場を理解した担当者が、用途・運用条件・予算に応じた最適な製品選定から導入までを一貫してサポートします。
【取扱内容】
●理化学機器(遠心機、インキュベーター等)
●細胞培養関連機器・周辺機器
●試薬・消耗品・ラボサプライ全般
●研究・医療現場向け設備・備品
正規代理店ルートによる調達のため、品質・保証・トレーサビリティを確保した安心な供給が可能です。
また、機器導入にあたっては、再生医療等安全性確保法や施設要件を踏まえた視点からの助言も行い、現場運用まで見据えた導入支援を提供します。
※機器単体の販売に加え、CPC構築・運用支援と組み合わせたご提案も可能です。
※研究用途・医療機関向けの正規ルートでの販売となります。

海外事業支援
海外技術・事業を日本制度に適合支援
海外の現地法人、および海外進出を検討している国内の法人向けへの事業支援を致します。
●現地での細胞加工施設導入支援
●現地での細胞加工施設管理・運営支援
●細胞培養加工施設の運営管理に関するノウハウ提供
●培養技術に関する等の知識提供
●高い技能の培養士の派遣による技術指導など
●現地での細胞加工施設維持・管理支援

顧問アサイン支援
再生医療・医療分野の専門顧問をアサイン
専門知識と客観的な視点を持つ外部顧問をアサインし、企業・医療機関が直面する課題解決および持続的な成長を支援します。ReGENETでは、再生医療・医療・化粧品分野における実務経験を有する専門家を中心に、事業フェーズや課題内容に応じた最適な顧問人材をご提案します。
【主なアサイン分野】
●再生医療等安全性確保法に精通した医療法顧問
●細胞治療・再生医療技術に強みを持つ技術顧問
●医療・ヘルスケア領域事業を支援する経営・事業顧問
●VCとの連携実績を持つ戦略・資金調達顧問
●臨床・検査・現場運用に精通した医療・検査系顧問
●人材育成を支援する医療従事者顧問 など
単なる名義貸しや形式的な顧問ではなく、現場・事業に実際に関与できる顧問人材のマッチングを重視しています。
<顧問アサイン支援>
※顧問は当社の外部パートナーとして参画します。
※契約形態は、当社を介した業務委託契約、または顧問との直接契約のいずれにも対応可能です。いずれの場合も、条件調整・業務設計は当社がサポートします。